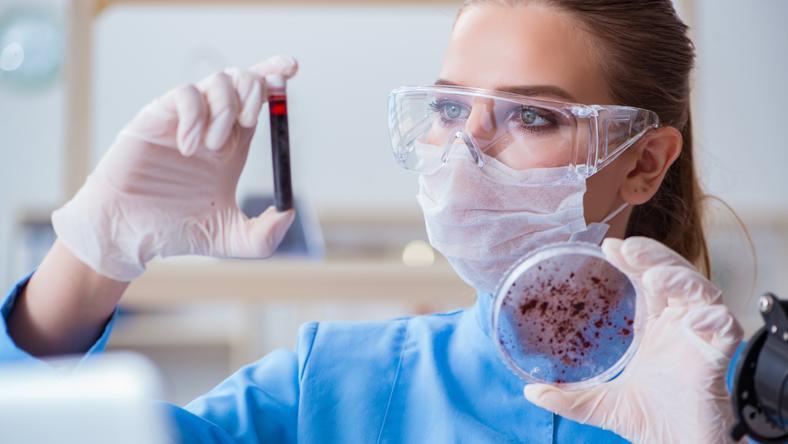
来认识一下伴随我们一生的微生物

本文来自微信公众号:Nature自然科研(Nature-Research),题图来自:图虫
除了构成我们身体的细胞外,人体内还有数以万亿计的微生物。这些微生物不仅包括帮助肠道消化的有益菌,还包括寄生在我们的皮肤上、口腔和阴道中的细菌。除了细菌,人体内还有各种病毒、真菌和古菌。
微生物定植是从何时开始的呢?大部分科学家认为,我们在出生时第一次接触到了细菌,而在出生以前,胎儿在一个无菌环境中发育;但是最近的一些研究发现,胎盘和包裹胎儿的羊水中有细菌的DNA,婴儿出生后的第一次胎便中也有细菌。
这能证明我们出生前就与细菌共生吗?有可能,但很多科学家认为这些结果是由污染引起的。
围绕这个问题的争议依然在继续,无论最终答案如何,所有人都一致认为,第一次主要定植发生于分娩中和分娩后不久。
顺产的婴儿在经过产道时,会获得一些来自母亲的细菌,出生后,婴儿会从空气中、与周围的物体以及人的接触中,获得更多的微生物。
在她成长的过程中,许多因素都会影响微生物组的构成,包括饮食、是否服用抗生素或其他药物、与多少人有过接触、是否养宠物、生活在什么地方,还可能包括她的基因组成。
乡村长大的儿童周围都是动物和尘土,这些儿童体内的微生物与城市长大的儿童不同。如果儿童没有暴露在各种各样的微生物中,他们似乎更容易患上自身免疫疾病和过敏,比如哮喘和湿疹。这种理论被称为卫生假说,它从一个方面证明了我们的微生物群会如何影响我们一生的健康。
成年时我们体内的微生物数量至少与人体细胞的数量一样多,我们的生理机能依赖这些群落。比如,它们可以帮我们抵御有害细菌,帮我们消化食物;微生物在分解食物的同时会产生名为代谢物的分子,这些代谢物会随血液循环抵达身体的各个组织,影响我们的代谢。
肠道菌群的多样化有利于代谢健康,多样性不足可能会导致炎症性肠病、肥胖和2型糖尿病。甚至有研究指出,微生物代谢物可以影响大脑和我们的精神健康。随着年龄增长,我们的微生物群会持续变化。研究显示,老年人的肠道微生物群与年轻的成年人不同,有可能会导致免疫系统和大脑功能发生年龄相关性变化。
未来仍需进一步认识与我们共生的各种微生物如何促进并影响我们的身心健康。我们需要更好地理解微生物为何会因人而异,以及这些差异会如何影响我们的生物学特征。尤其重要的是,我们需要更多地研究非白人群体和世界其他地区人群的微生物。
有一点毋庸置疑:没有这些微生物,就没有我们。
本文来自微信公众号:Nature自然科研(Nature-Research)